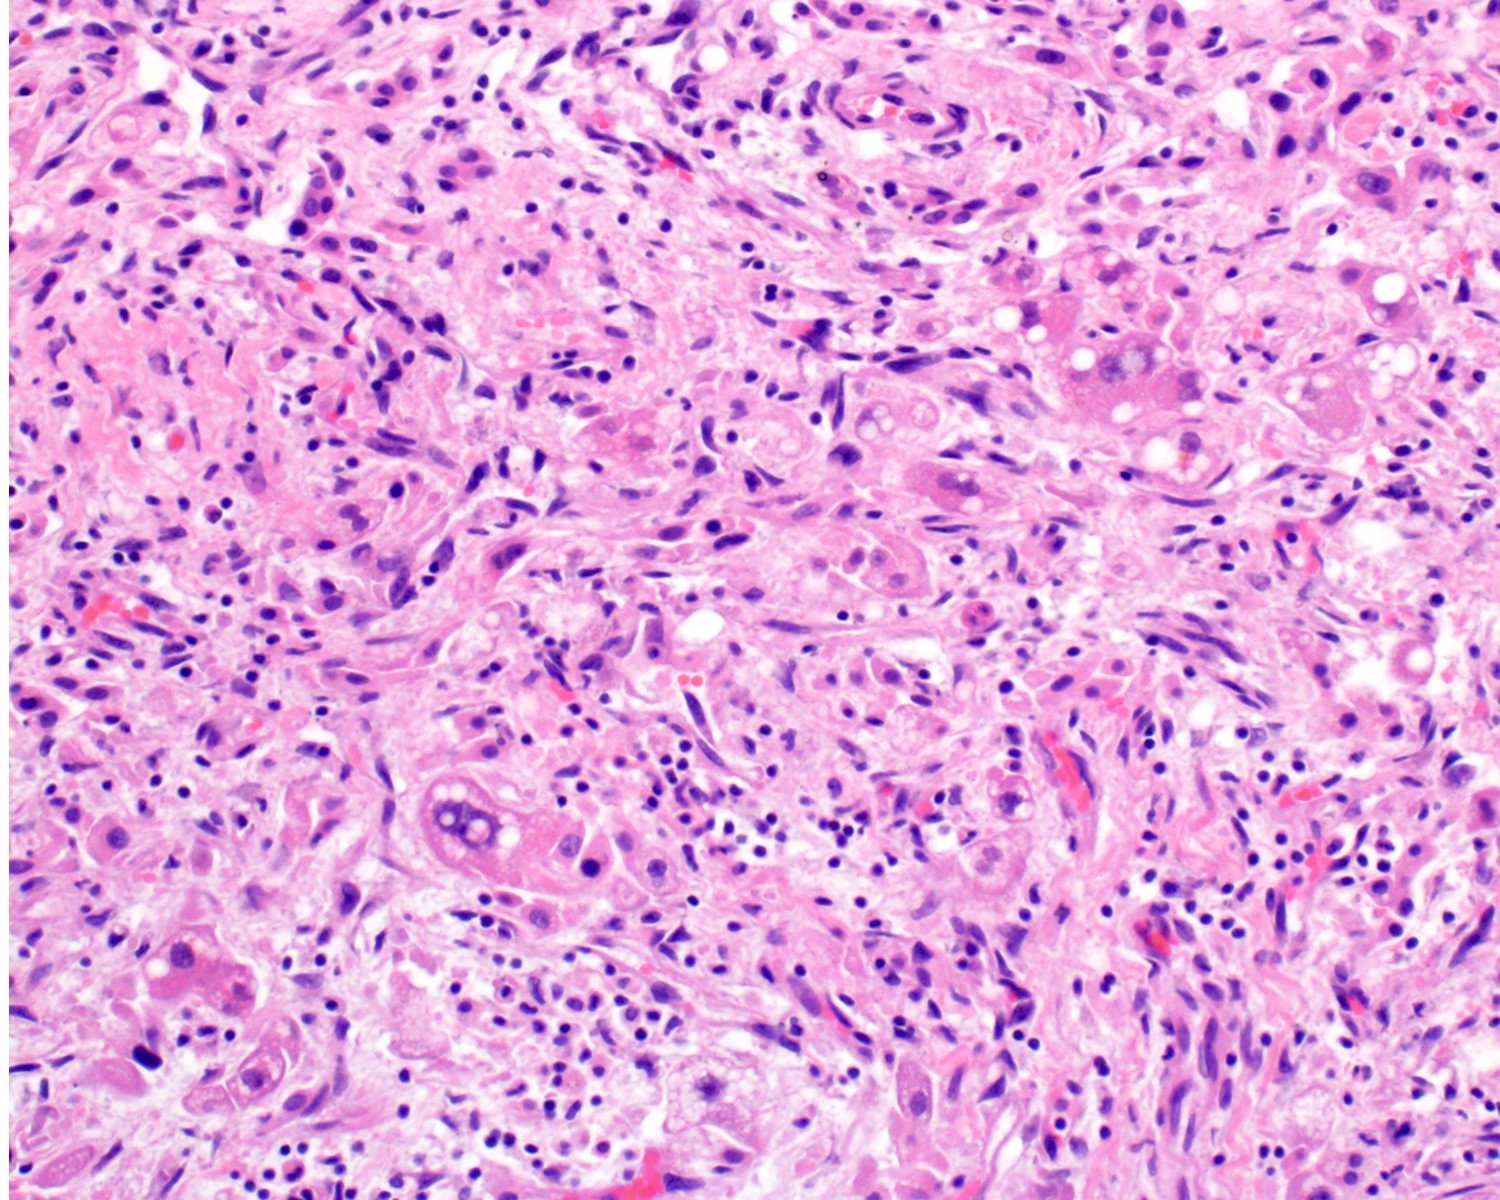
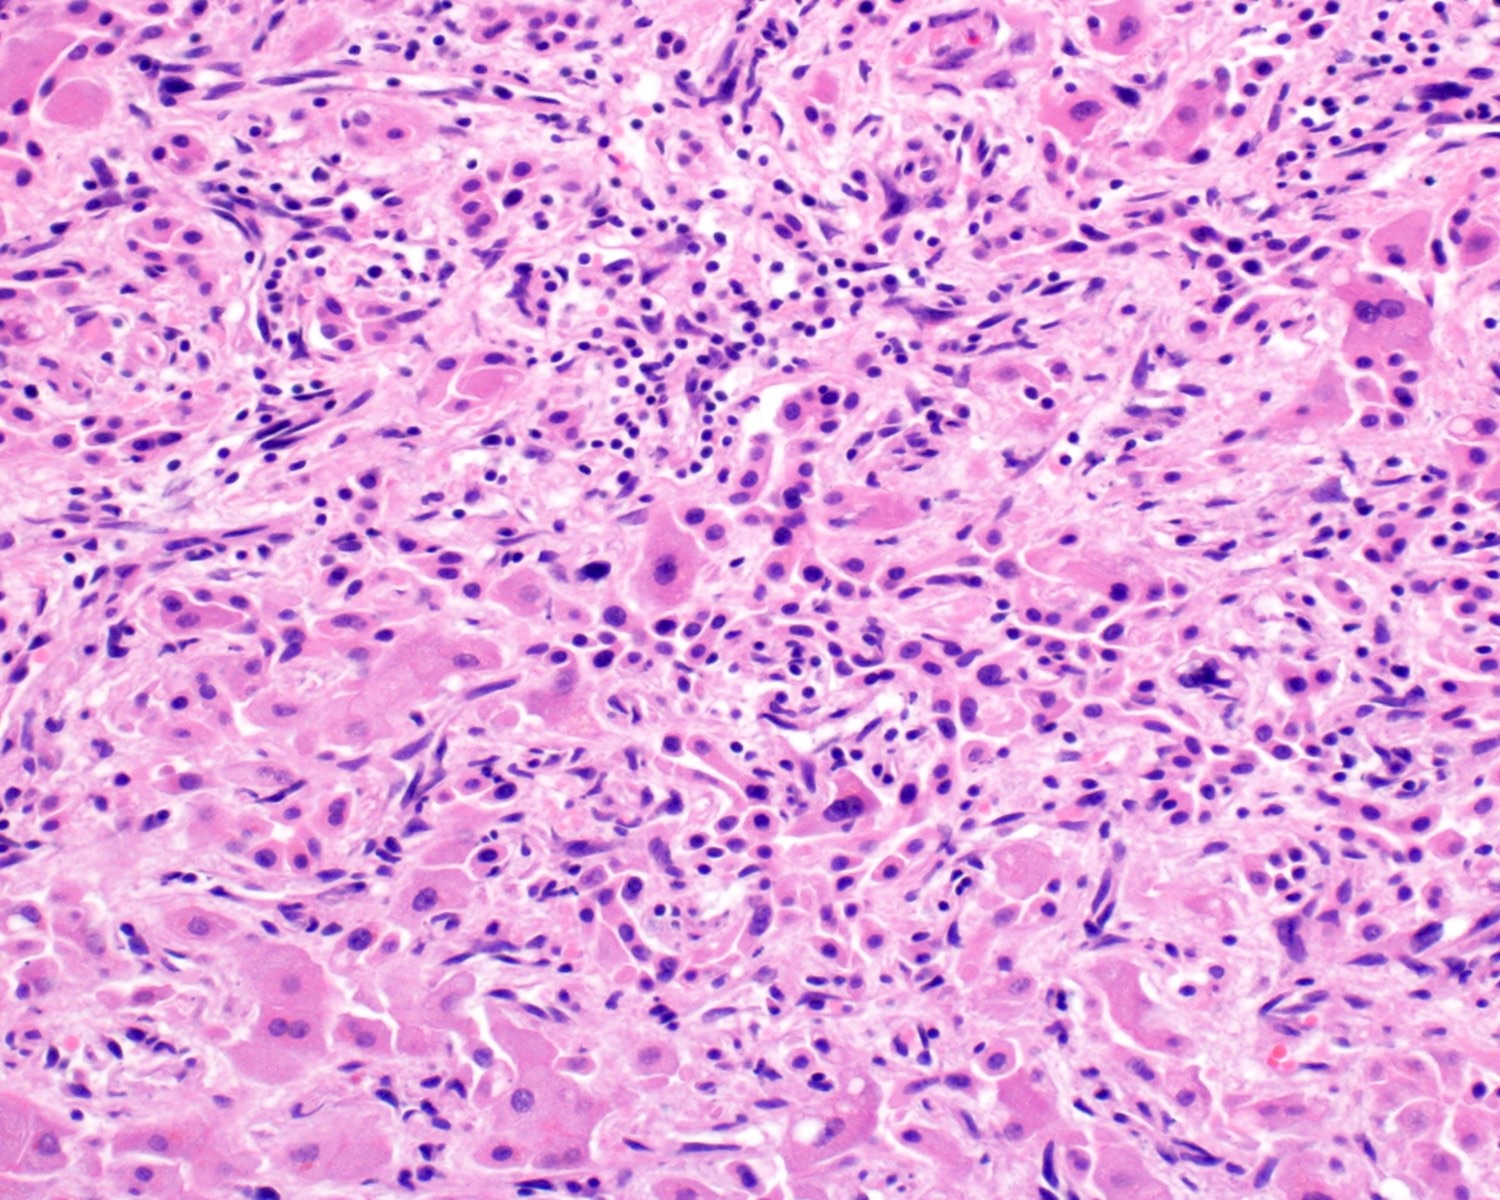
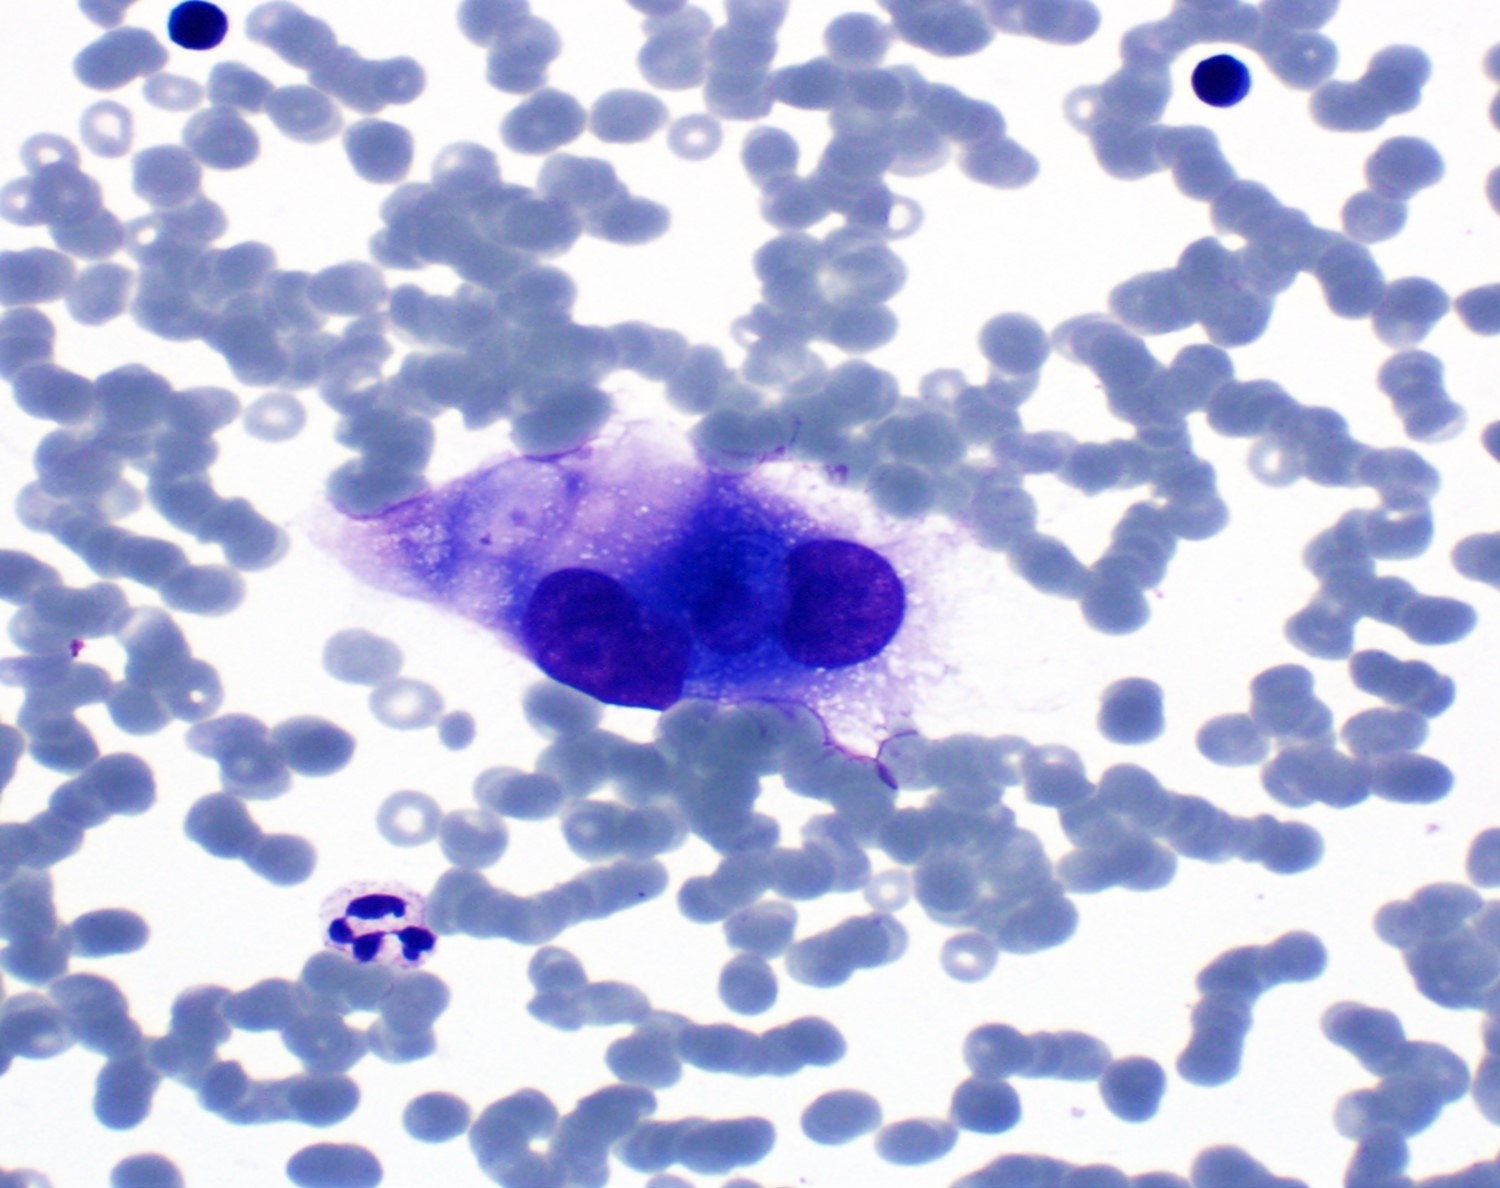

Table of Contents
Definition / general | Essential features | Terminology | ICD coding | Epidemiology | Sites | Pathophysiology | Etiology | Clinical features | Diagnosis | Laboratory | Radiology description | Radiology images | Prognostic factors | Case reports | Treatment | Gross description | Gross images | Microscopic (histologic) description | Microscopic (histologic) images | Cytology description | Cytology images | Positive stains | Negative stains | Electron microscopy description | Molecular / cytogenetics description | Videos | Sample pathology report | Differential diagnosis | Additional references | Practice question #1 | Practice answer #1 | Practice question #2 | Practice answer #2Cite this page: Herman M, Shi J. Angiosarcoma. PathologyOutlines.com website. https://www.pathologyoutlines.com/topic/livertumorangiosarcoma.html. Accessed October 3rd, 2025.
Definition / general
- Rare malignant neoplasm with endothelial differentiation and vasoformation
Essential features
- Atypical vascular channels: irregular, anastomosing channels lined by atypical endothelial cells
- Endothelial cell atypia: pleomorphism, hyperchromatic nuclei, increased mitotic activity and prominent nucleoli; cells may appear spindle shaped or epithelioid
- Cellularity and architecture: variably cellular, with areas of solid growth interspersed with vascular channels; formation of papillary structures or solid nests in some areas
- Necrosis and hemorrhage: frequent areas of hemorrhage and extensive necrosis within the tumor
- Positive for endothelial markers: CD31, CD34, factor VIII related antigen, ERG (an endothelial transcription factor)
Terminology
- Hemangiosarcoma
- Malignant angioendothelioma
- Malignant hemangioendothelioma
- Lymphangiosarcoma
ICD coding
Epidemiology
- Accounts for up to 2% of primary hepatic malignancies (Eur J Surg Oncol 2015;41:1137)
- Most common primary malignant mesenchymal neoplasm of the liver in adults (Eur J Surg Oncol 2015;41:1137)
- Incidence of 0.5 - 2.5 per 10 million
- Men in seventh decade of life (Am J Surg Pathol 2009;33:264)
- M:F = 3 - 4:1 (Ann Med Surg (Lond) 2024;86:1601)
Sites
- Liver
Pathophysiology
- Recurrent somatic mutations involving angiogenic signaling pathways (e.g., KDR, PTPRB and PLCG1 mutations) are present in ~40% of cases (Nat Genet 2014;46:376, Cancer Res 2009;69:7175, J Surg Oncol 2008;97:74)
- Mutations in RAS genes, PIK3CA, TP53, FLT4 and TIE1 are rare (Cancer 2012;118:5878, Nat Genet 2014;46:376)
- Frequently associated with ATRX deficiency, leading to lengthened telomeres (Hum Pathol 2015;46:1360)
- Vinyl chloride associated hepatic angiosarcomas due to TP53 mutations (Carcinogenesis 1995;16:2879)
Etiology
- Industrial exposure: vinyl chloride monomer (VCM) (BMC Gastroenterol 2011;11:142)
- Radiocontrast (Thorotrast)
- Androgenic steroids (Lancet 1979;2:1249)
- Phenylhydrazine (Curr Oncol 2022;29:3637)
- Arsenic (BMC Gastroenterol 2011;11:142)
- Radiation (Cureus 2018;10:e3283)
- 75% are idiopathic (Ann Med Surg (Lond) 2024;86:1601)
Clinical features
- Abdominal pain and mass (Case Rep Gastroenterol 2020;14:137, Am J Surg Pathol 2004;28:298)
- Nausea, vomiting, anorexia, fatigue (Case Rep Gastroenterol 2020;14:137)
- Ascites (Pediatr Pathol 1992;12:485)
- Hepatomegaly (Case Rep Gastroenterol 2020;14:137)
- Bowel obstruction
- Jaundice (Case Rep Gastroenterol 2020;14:137)
- Liver failure
- Liver rupture and hemoperitoneum
- Metastasis (Ann Med Surg (Lond) 2024;86:1601)
- Asymptomatic (Case Rep Gastroenterol 2020;14:137)
Diagnosis
- Malignant endothelial histology
- Nuclear pleomorphism
- Vascular immunohistochemistry
- Reference: Histol Histopathol 2021;36:3
Laboratory
- Nonspecific elevated liver function tests (LFTs) and bilirubin
Radiology description
- Ultrasound: peripheral echogenicity and central hypoechoic appearance; color Doppler study shows hypervascularity of the tumor (World J Gastroenterol 2017;23:2443)
- Noncontrast computed tomography (CT): hypoattenuating masses with focal hyperattenuation, suggestive of hemorrhage; hyperattenuating linear meshwork in Thorotrast cases
- Contrast CT: heterogeneous irregular enhancement consistent with necrosis and fibrosis; disorganized, patchy enhancement in later phases (Br J Radiol 2017;90:20170039)
- Magnetic resonance imaging (MRI) T1 / T2: heterogeneous areas of high signal, indicating a mix of tumor tissue and hemorrhage (Radiopaedia: Hepatic Angiosarcoma [Accessed 29 October 2024])
Prognostic factors
- Overall, poor prognosis due to advanced stage of disease at the time of presentation
- Survival time is usually < 1 year
- Poor prognostic factors include older age, large tumor size and high Ki67 index (Am J Surg Pathol 1998;22:683)
Case reports
- 54 year old man with dyspnea (Cureus 2018;10:e3283)
- 71 year old man with hepatic angiosarcoma (Cureus 2020;12:e6848)
- 75 year old woman with right upper quadrant abdominal pain (World J Clin Cases 2022;10:11590)
Treatment
- Liver resection
- Liver transplantation contraindicated
Gross description
- Hemorrhagic and ulcerated single, multiple or diffuse masses
- Can be poorly defined with diffuse liver parenchymal involvement and often splenic extension (Radiology 2005;235:106)
- Mean size: 7.9 cm; range: 2.0 - 28.0 cm (Am J Surg Pathol 2019;43:581)
Gross images
Microscopic (histologic) description
- 2 main histologic growth patterns were described (Am J Surg Pathol 2019;43:581)
- Non-mass forming
- Sinusoidal
- Dilated sinusoids lined by atypical endothelial cells seen in angiosarcoma with hyperchromatic nuclei
- Peliotic
- Blood pools and fibrin surrounded by hepatocytes
- Peripheral clusters of atypical endothelial cells seen in angiosarcoma mixed with inflammatory cells may extend into the sinusoids
- Sinusoidal
- Mass forming
- Vasoformative shows architectural complexity and interconnecting vascular channels
- Anastomosing vessels and haphazard vascular channels
- Endothelial cells show tufting, atypia and mitotic figures
- Nonvasoformative shows epithelioid to spindled morphology
- Epithelioid morphology (epithelioid angiosarcoma) is most common (Am J Surg Pathol 2004;28:298)
- Solid nests or sheets of tumor cells
- Tumor often invades into sinusoids and hepatic venules at the periphery
- Cells have eosinophilic cytoplasm and oval nuclei
- Chromatin can be vesicular
- Multinucleated giant cells can be present
- Vasoformative shows architectural complexity and interconnecting vascular channels
- Non-mass forming
- Unusual growth patterns (Am J Surg Pathol 2019;43:581)
- Whorls of spindle cells in a background of chronic inflammation and loose myxoid to sclerotic stroma
- Infantile hemangioma-like angiosarcoma
- Hemangioma-like angiosarcoma
Microscopic (histologic) images
Cytology description
- Well differentiated tumors have elongated cells, isolated cells, tightly cohesive clusters or syncytia (Cibas: Cytology - Diagnostic Principles and Clinical Correlates, 4th Edition, 2014)
- Poorly differentiated: large spindle shaped or epithelioid shaped pleomorphic nuclei (Cibas: Cytology - Diagnostic Principles and Clinical Correlates, 4th Edition, 2014)
- Rhabdoid forms may occur in some epithelioid angiosarcomas (Cibas: Cytology - Diagnostic Principles and Clinical Correlates, 4th Edition, 2014)
- Discohesive epithelioid cells with nuclear pleomorphism and occasional spindle cells (Cibas: Cytology - Diagnostic Principles and Clinical Correlates, 4th Edition, 2014)
- Variably cellular with necrotic background (Cancer Cytopathol 2016;124:659)
- Dense cytoplasm with cytoplasmic vacuoles containing red blood cells (erythrophagocytosis) or neutrophils (Cancer Cytopathol 2016;124:659)
- Endothelial wrapping suggestive of vascular channel formation (Cancer Cytopathol 2016;124:659)
- Large, atypical round to oval nuclei with prominent bar shaped nucleoli (Cancer Cytopathol 2016;124:659)
- Multinucleated tumor giant cells with atypical mitotic figures (Cancer Cytopathol 2016;124:659)
Cytology images
Positive stains
- ERG (nuclear)
- CD31 (membranous)
- CD34 (variable ~50%)
- Factor VIII
- VEGF (Sci Rep 2021;11:9362)
- FLI1
- Ulex europaeus agglutinin I (UEA1) (Histopathology 1986;10:1153)
- D2-40 (podoplanin)
Negative stains
- Cytokeratin (Ann Surg Oncol 2019;26:576)
- EMA (Histopathology 2014;64:101)
- CD30 (~33% of cases have membranous staining) (Appl Immunohistochem Mol Morphol 2014;22:358)
- HHV8 (Pathology 2005;37:284)
- KIT / CD117 (Int J Clin Exp Pathol 2014;7:1012)
- Smooth muscle actin (SMA) (Arch Pathol Lab Med 2011;135:268)
- Desmin (Histopathology 2014;64:101)
- DOG1 (Pathol Res Pract 2021;228:153663)
- A potential pitfall with the epithelioid subtype is the expression of keratin or EMA, as they are not always negative and should be interpreted carefully
Electron microscopy description
- Weibel-Palade bodies characterized by a single membrane and dense interior with rod shaped profiles in the cytoplasm of neoplastic cells (Toxicol Pathol 2012;25:273)
Molecular / cytogenetics description
- Most carry complex karyotypes with no recurrent chromosomal changes (Genes Chromosomes Cancer 2015;54:72)
- ~40% of cases harbor recurrent somatic mutations in genes involved in angiogenesis (e.g., KDR, PTPRB and PLCG1) with rare mutations in RAS genes, PIK3CA, TP53, FLT4 and TIE1
- TP53 mutations are associated with vinyl chloride associated hepatic angiosarcoma
- KRAS mutations in sporadic cases as well as cases associated with Thorotrast exposure (Lab Invest 1997;76:153)
Videos
Angiosarcoma
Sample pathology report
- Liver, resection:
- Angiosarcoma (see comment)
- Comment: Immunohistochemical stains were performed and the neoplastic cells are positive for ERG and CD31, while negative for cytokeratin, CD117, DOG1 and SMA, supporting the above diagnosis.
Differential diagnosis
- Hepatocellular carcinoma (Pathologica 2021;113:203):
- Most common primary liver malignancy
- Hepatocyte-like cells in trabecular, pseudoglandular or solid patterns with nuclear atypia and frequent vascular invasion
- Fibrolamellar variant, seen in younger patients without liver disease, features large eosinophilic cells in fibrous stroma
- Positive for HepPar1, arginase1 and glypican 3
- Negative for vascular markers
- Associated with chronic liver disease, including hepatitis B and C, cirrhosis and nonalcoholic fatty liver disease (NAFLD)
- Epithelioid hemangioendothelioma (Diagn Pathol 2014;9:131):
- Rare, low to intermediate grade vascular tumor
- Epithelioid endothelial cells in a myxohyaline stroma, often forming ill defined vascular channels and intracytoplasmic lumina
- Usually found incidentally, with imaging typically revealing multiple nodules and peripheral enhancement
- Occasionally positive for epithelial markers (CK8/18)
- WWTR1::CAMTA1 or YAP1::TFE3 rearrangement
- Kaposi sarcoma (Ann Hepatobiliary Pancreat Surg 2023;27:329):
- Rare malignancy of immunocompromised individuals and HIV / AIDS patients
- Multiple nodules or diffuse infiltration
- Spindle cell proliferation, slit-like vascular spaces, extravasated red blood cells and hemosiderin deposits, with a mixed inflammatory infiltrate
- Positive for HHV8 (LANA1)
- Hemangioma (Ann Hepatobiliary Pancreat Surg 2023;27:329):
- Circumscribed, well defined benign vascular proliferation
- No significant atypia or mitotic figures
Additional references
Practice question #1
A 55 year old man presents with abdominal pain, weight loss and hepatomegaly. Laboratory studies reveal elevated liver enzymes but normal alpha fetoprotein levels. A liver core needle biopsy is performed. ERG immunohistochemistry is shown in the second image above. What is the most likely diagnosis?
- Cholangiocarcinoma
- Hemangioma
- Hepatic adenoma
- Hepatocellular carcinoma
- Liver angiosarcoma
Practice answer #1
E. Liver angiosarcoma. The histopathology shows nests and sheets of highly atypical neoplastic cells with hyperchromatic and pleomorphic nuclei, which are highlighted by ERG immunohistochemistry in the second image above. This makes liver angiosarcoma the most likely diagnosis.
Answer D is incorrect because hepatocellular carcinoma is less likely as the histology is more likely to show atypical hepatocytes in trabecular to solid patterns. This tumor stains positive for HepPar1, arginase1 and glypican 3 and negative for ERG.
Answer A is incorrect because cholangiocarcinoma morphologically shows atypical glands that infiltrate in between the hepatic cords. This would stain positive for CK7. ERG would be less helpful in making the diagnosis of cholangiocarcinoma. Additionally, the history would include a hepatic mass arising from the biliary ducts.
Answer C is incorrect because hepatic adenoma is a benign tumor that is more common in women. This well circumscribed lesion would show a proliferation of hepatocytes with no atypia, atypical mitoses or hepatic invasion.
Answer B is incorrect because hepatic hemangiomas are benign tumors that occur more commonly in women. This circumscribed lesion would have no cytologic atypia or mitoses, as compared to angiosarcoma.
Comment Here
Reference: Angiosarcoma
Comment Here
Reference: Angiosarcoma
Practice question #2
A 62 year old man with a history of alcohol use, hepatitis B and exposure to vinyl chloride and Thorotrast presents with fatigue, abdominal discomfort and significant unintentional weight loss. Imaging studies reveal multiple irregular hypodense lesions in the liver. A liver biopsy is performed, showing atypical spindle cells with necrosis and areas of hemorrhage. Immunohistochemical staining shows the tumor cells are positive for factor VIII related antigen and CD31. Which of the following risk factors is most strongly associated with this patient's diagnosis?
- Aflatoxin exposure
- Chronic alcohol consumption
- Hepatitis B infection
- Iron overload
- Vinyl chloride exposure
Practice answer #2
E. Vinyl chloride exposure is most commonly associated with hepatic angiosarcoma. Answer B is incorrect because chronic alcohol consumption is associated with cirrhosis and hepatocellular carcinoma. Answers A, C and D are incorrect because aflatoxin exposure, hepatitis B infection and iron overload (hemochromatosis) are associated with hepatocellular carcinoma.
Comment Here
Reference: Angiosarcoma
Comment Here
Reference: Angiosarcoma